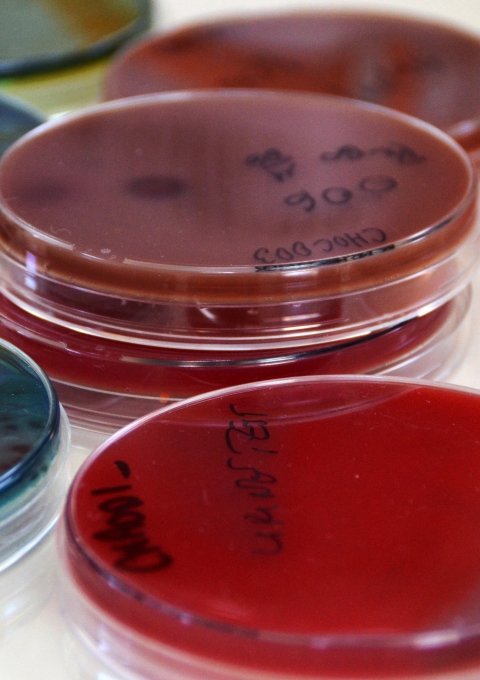
o diagnose all bacterial diseases which are affected children. The laboratory also includes a blood bank. In 2013, more than 1,600 bags had been collected of which 16% provided by volunteer donors. On 14 June 2014, MSF organized, in partnership with the Ministry of Health, various promotional activities to promote voluntary blood donation, on the occasion of the World Blood Donor Day.

AMR remains a leading cause of death worldwide nearly a decade after UN member states agreed to make it a priority
Geneva/New York, 25 September 2024 – Ahead of the second-ever United Nations (UN) High Level Meeting on antimicrobial resistance* (AMR) tomorrow, where world leaders will come together to agree on commitments to advance the global response to AMR, Médecins Sans Frontières/Doctors Without Borders (MSF) called on governments to take swift, bold action to translate this political declaration into meaningful progress against drug resistance. Headway against AMR since the first declaration nearly a decade ago has been inadequate and inequitable, with low- and middle-income countries – and humanitarian contexts, in particular – least equipped to respond despite bearing the highest burdens of drug-resistant infection. Drawing on years of experience tackling drug resistance around the world, MSF urged governments to build on the commitments made and take an ambitious set of follow-on steps to empower those most affected by AMR to prevent, detect, and respond to it. AMR is a leading cause of death worldwide, and contributed to 4.95 million deaths in 2019 alone, with recent estimates showing the threat is still growing at alarming rates, possibly contributing to 8.2 million deaths annually by 2050.
“We are seeing staggering rates of drug-resistant infections in many of the low-resource and humanitarian settings where we work, in large part because healthcare workers don’t have what they need to prevent, detect, and respond to AMR,” said Dr Christos Christou, International President of MSF. “The UN Political Declaration on antimicrobial resistance is a welcome step towards strengthening the global AMR response and expresses important aspirations for global equity and solidarity. Considering the magnitude of the challenge of AMR though, and how few of the hardest-hit countries have been able to fund and implement national action plans, the declaration text should have been much more concrete and ambitious. The declaration must now go beyond words on paper: governments must not only enact and be accountable to the commitments they’ve made, but they must also build on and refine them to ensure low-resource and humanitarian settings are no longer left behind.”
People in low- and middle-income countries experience the highest rates of AMR and infectious diseases globally, but are the least likely to have access to healthcare, including the medicines, vaccines, and diagnostics they need. In humanitarian settings, other factors compound the AMR crisis. Conflicts or natural disasters, for example, can result in traumatic injuries that can easily become infected and force people to take refuge in overcrowded settings where resistant bacteria can spread easily.
In the political declaration, governments acknowledged the importance of addressing AMR in humanitarian settings like those in which MSF works, as well as several issues that MSF has highlighted as key priorities in responding to AMR. However, the commitments made to address these issues should have been bolder and more precisely calibrated to address global inequities. MSF recommends that governments build on and refine these commitments in the following ways:
- The declaration’s commitment to include affected communities and humanitarian organisations in the governance of platforms and mechanisms to address AMR must now be put into practice. Only by ensuring the inclusive participation of these groups in global AMR initiatives can an effective roadmap for reaching the most underserved settings take shape. For example, if established, the proposed Independent Panel on Evidence for Action Against AMR must adhere to principles of impartiality, transparency, and accountability to all countries, and prioritise research in and for communities most affected by AMR. This is important, because communities in conflict-affected, fragile and humanitarian settings are more vulnerable to AMR, but evidence needed to inform the response in these settings is acutely lacking.
- The declaration recognizes the need for strengthening laboratory capacity and commits to “improve access to diagnosis and care,” but this broad commitment must be made more specific and precise in follow-on agreements and accountability frameworks to ensure expanded and equitable availability of quality-assured microbiology laboratories. Access to microbiology laboratories is a critical foundation for preventing, detecting and controlling AMR more effectively, but many places with high rates of AMR do not have quality laboratories.
- The commitment to increased international financing and technical assistance to enable low- and middle-income countries to implement national action plans to address AMR must result in stronger and more ambitious funding, as the currently proposed US$100 million to see 60 per cent of countries achieve funded plans to tackle AMR by 2030 is not sufficient to address a health issue of this magnitude.
- The commitment to ensure timely and equitable access to affordable medical tools, including antimicrobials and diagnostic tests, must translate into concrete action. The significant global gaps in access to medical tools must be tracked and quantified to guide efforts to achieve more equitable access, and resources allocated accordingly for both access strategies and antimicrobial stewardship programs. Furthermore, when governments provide funding for research and development for new antimicrobials, they should prioritise public and nonprofit initiatives, as these facilitate access, stewardship, and collaborative approaches to research. Funders must also attach upfront conditions ensuring equitable global access to any resulting medical tools into agreements when providing the “push” and “pull” funding called for in the declaration.
"To effectively combat AMR globally, governments must address the significant discrepancies in the amount of evidence for action available in high-income and low-resource settings,” said Dušan Jasovský, Antimicrobial Resistance Pharmacist with the MSF Access Campaign. "This means that the Independent Panel on Evidence for Action Against AMR proposed in the declaration must prioritise research in communities most affected by AMR, which are often in humanitarian or low-resource settings where there is currently the least evidence to guide action. This panel is in a great position to inform a response to drug resistance in the hardest-hit areas based on interventions that work, but to do so it must operate with transparency, accountability, and impartiality, backed by ambitious financial means of implementation, and in close collaboration with affected communities."
####
*AMR — when microbes like bacteria, viruses, and fungi evolve and survive despite the antimicrobial medicines, such as antibiotics, used against them — can make medical care less effective and much more difficult, prolonged, and costly for patients and treatment providers.
MSF is a leading actor in preventing, detecting, and responding to AMR in humanitarian settings, with infection prevention and control, and stewardship initiatives across multiple contexts and 50 sites with planned or existing access to diagnostic microbiology in 20 countries worldwide. MSF has developed an interdisciplinary approach to addressing AMR which includes targeted training and support for infection prevention and control, and antimicrobial stewardship, and in some cases also efforts to provide access to microbiology lab-based diagnosis.








